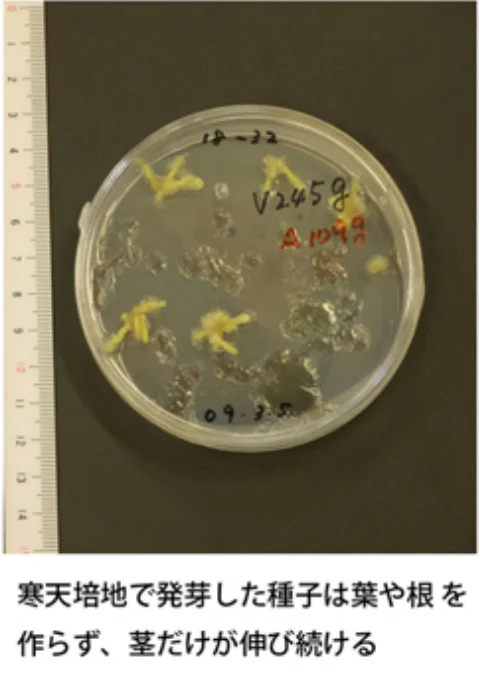
寒天培地

光合成する植物と光合成しない植物の雑種が世界ではじめて開花
光合成する植物と光合成しない植物の雑種が世界ではじめて開花

国立科学博物館筑波実験植物園では、光合成する植物と光合成しない植物の雑種の開花に世界で初めて成功しました。2012年10月26日(金)に、プレスリリースでも報告をいたしました。
咲いた植物はランの仲間で、正常な葉をつけて光合成をおこなうスルガラン(Cymbidium ensifolium)と葉がなくて光合成をおこなわないマヤラン(Cymbidium macrorhizon)の雑種です。2006年8月に交配。栄養の入った寒天培地で播種・培養し、開花に6年を要しました。この植物が正常な葉をつけて光合成をおこなうかどうかはまだ分かりません。
ふつう植物は葉で光合成をおこない、生きていくための栄養を作ります。ところが、マヤランのように光合成をやめ葉を作らない植物がまれにあるのです。こうした光合成しない植物がどのような道すじをたどって進化したのか、これまでまったく分かっていません。この謎を解き明かす有力な方法が、雑種とその子孫を育てて、個体ごとの性質と遺伝子の関連を調べることです。今回の成功をきっかけに、光合成をやめるという奇妙な進化の解明が進むことが期待されます。
今回のホットニュースは、世界ではじめて開花したこの興味深い雑種のランについてとりあげます。
「根も葉もない」植物のふしぎ

雑種の両親はどんな植物なのか、お話ししましょう。どちらも花屋さんの店先にならぶシンビジウムの仲間です。母親のスルガランは、九州より南、熱帯アジア、さらにはニューギニアまで広く分布する林の下草です。長い葉を付け、正常に光合成をおこないます。父親のマヤランは関東地方から西の林に生え、海外では中国からヒマラヤにかけて分布しています。こちらは根も葉もない植物です。根がないから水を取り込むことができないですし、葉がないから光エネルギーを受けとめることができません。つまり、まともに光合成できないということです。
なぜこんな根も葉もない植物が進化したのでしょうか?それは菌類から水や栄養をもらっているからです。菌に寄生する仕組みを発達させるとともに光合成をやめてしまい、根や葉を作らない進化をとげたのでしょう。こうした方法で生きぬく植物を菌従属栄養植物と呼びます。
さて、こうしたまったく性質の違うふたつの植物の雑種ができた理由、それは両者が縁の近い種類だからです。
遊川先生 私の研究 「共生菌からみたマヤランの不思議な暮らし」(HTML)
へんな雑種ができるまで
生物が種をこえて交雑し子供が生育することは、簡単ではありません。ましてや光合成をするかしないかという、栄養を作る仕組みのまったく違う種の雑種を作ることはとても難しそうです。
そこで作戦を練りました。できる限り縁の近い2つの種類を選んで交配すれば、遺伝子に共通する部分が多いので雑種の開発が成功する可能性は高くなるはずです。光合成する植物としない植物でこうしたペアがないか調べたところ、マヤランはスルガランなどの光合成するシュンラン属と遺伝的な違いがわずかしかないことが分かったのです。ここがポイントで、世界中の光合成しない植物の中で、光合成する植物との遺伝的な違いがわずかである種はほとんどありません。また多くの光合成しない植物は栽培できなかったり、稀少なため見つけることができないなど、交配すること自体が難しいのです。
10年くらい前からなんどか交配を繰り返し、ようやく2006年8月、交配に成功しました。発芽した66本の苗の生育はいたってマイペースで、ちょうど6年たった今年の8月、最初の花が咲きはじめたのです。
いま雑種の花を交配して次の世代を作ることを試みています。2代目が育てば、個体ごとの性質と遺伝子の関連を調べて、「根も葉もない」世にも奇妙な植物の進化を解き明かすことが期待できます。
遊川先生 私の研究 「共生菌からみたマヤランの不思議な暮らし」(HTML)
「根も葉もない」進化の解明へ

根も葉もない、光合成もしないというと、生き物として退化した存在のように感じますが、ほかの生き物から栄養を横取りして生きるのは、実は巧妙で洗練されたやり方です。そして植物が光合成しないということは、植物が植物をやめるに等しい大胆な進化とも言えます。
これまで葉を失う進化=光合成をしない植物の進化と考えられてきましたが、実際には、根を作らない性質、地下の茎に共生菌のすむ場所を提供する仕組み、共生菌をだましながら栄養をうばい取る仕組み、反対に共生菌に食べられてしまわないよう防衛する仕組み、菌からのわずかな栄養でも生きていけるよう体を小さくし短い時間で開花し実をむすぶ仕組みなど、さまざまな特性が進化してはじめて、植物は光合成せずに生育することができるのです。
つまり「根も葉もない」進化は、あるひとつの遺伝子が変化してできるようなシンプルなものでないので、今回開発した植物を使った遺伝子解析が重要な意味を持つのです。
そして植物が菌を巧妙に利用して栄養を奪い取る仕組みが遺伝子のレベルで分かれば、光合成に適さない暗い場所での農業や、作物が炭水化物を生産する性能を上げることにつながるかもしれません。
植物研究部 多様性解析・保全グループ(筑波実験植物園) 遊川 知久